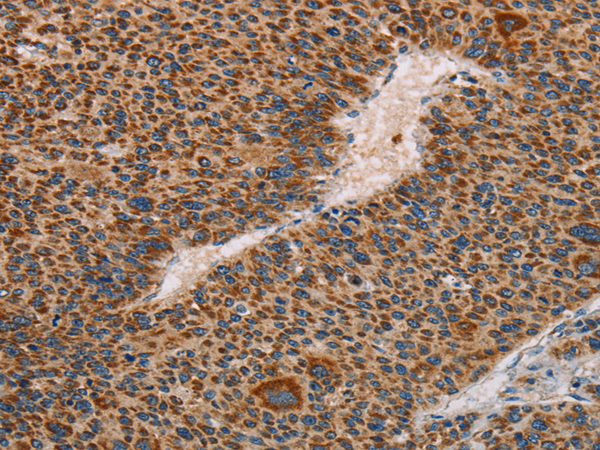
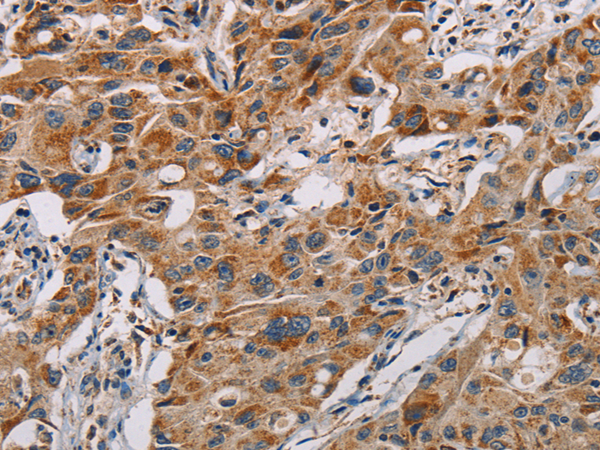
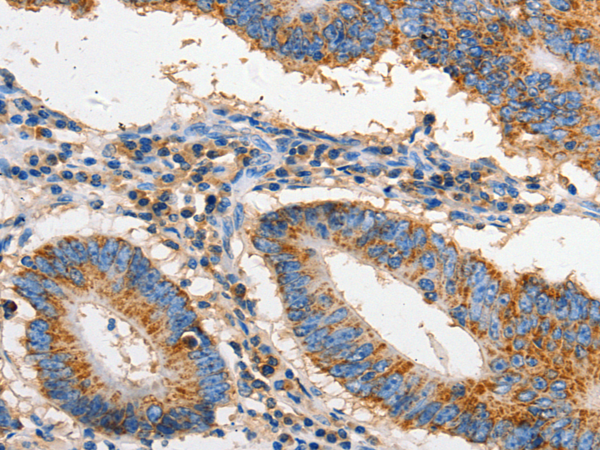

-
分类: 科研抗体货号: P07039别名: MAA2; ANOP2; MCOPS2应用: IHC反应种属: Human, Mouse
-
分类: 科研抗体货号: P07008别名: SL-1, STMY, STR1, CHDS6, MMP-3, STMY1应用: IHC反应种属: Human
-
分类: 科研抗体货号: P07038别名:应用: WB反应种属: Human, Mouse, Rat
-
分类: 科研抗体货号: P07007别名: CLG; CLGN应用: WB,IHC反应种属: Human
-
分类: 科研抗体货号: P07035别名: HAP; BAG-1; RAP46应用: WB,IHC反应种属: Human
-
分类: 科研抗体货号: P07006别名: APT1; CD95; FAS1; APO-1; FASTM; ALPS1A; TNFRSF6应用: WB,IHC反应种属: Human
-
分类: 科研抗体货号: P07034别名: APIP2, CGI29, CGI-29, MMRP19, dJ179L10.2应用: WB,IHC反应种属: Human, Mouse
-
分类: 科研抗体货号: P07004别名: CREB应用: IHC反应种属: Human, Mouse, Rat
-
分类: 科研抗体货号: P07031别名: IKBA; MAD-3; NFKBI应用: WB反应种属: Human, Mouse, Rat
-
分类: 科研抗体货号: P07003别名: STAT6B; STAT6C; D12S1644; IL-4-STAT应用: WB反应种属: Human, Mouse

鄂公网安备42018502007531号
鄂公网安备42018502007531号

